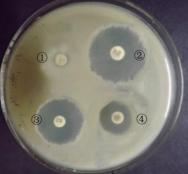
2022年下半年教师资格证考试《高中生物》题(图1)

下列关于原核细胞和真核细胞的叙述,正确的是( )。
将紫色洋葱鳞片叶表皮浸润在一定浓度的蔗糖溶液中,在显微镜下观察到细胞发生了质壁分离。下列叙述不正确的是( )。
缺
缺
缺
缺
缺
缺
缺
缺
缺
缺
缺
缺
缺
缺
在“腐乳的制作”实验中,下列叙述正确的是( )。
基因工程中因受体细胞不同,目的基因导入的方法也不同,下列叙述不正确的是( )。
为了研究某种抗生素的抑菌效果,在培养大肠杆菌的平板培养基上,分别放置了4个经过不同浓度抗生素处理的圆形滤纸片。培养一段时间后,产生的抑菌圈如下图。下列判断正确的是( )。
多组黄色小鼠(AvyAvy)与黑色小鼠(aa)杂交,F1中小鼠表现出不同的体色,是介于黄色和黑色之间的一些过渡类型。经研究,不同体色小鼠的Avy基因中碱基序列相同,但某些核苷酸有不同程度的甲基化现象。甲基化程度越高,Avy基因的表达受到的抑制越明显。下列叙述不正确的是( )。
讲解技能是教学的基本技能,下列叙述不正确的是( )。
从科学发展的历程来看,最早使用的科学过程技能是( )。
下列大概念不属于《普通高中生物学课程标准(2017年版2020年修订)》规定的必修课程学习内容的是( )。
某师范生拟对新入职的生物学教师开展“职业适应现状及成因分析”的研究,所采用的研究方法中不恰当的是( )。
下列做法属于增值评价的是( )。
某研究小组进行了如下实验:将某植物的叶片放入密闭系统中,保证各实验组温度相同。在不同光照强度下观测系统内
浓度随时间的变化,结果如下图所示。

问题:
(1)在光照强度为300lx时,密闭系统中的
浓度维持不变,原因是______。(3分)
(2)比较不同光照条件下实验进行的第1h内叶片净光合速率的大小,可以得出结论:光照强度越强,叶片净光合速率______。(3分)
(3)随着光照强度的提高,该植物叶片的
补偿点______(填“逐渐增大”“保持不变”或“逐渐减小”)。判断的依据是______。(6分)
(4)该实验目的是探究______。(3分)
鸡是ZW型性别决定的鸟类,其羽色分为芦花与非芦花两种,该性状仅由一对Z染色体上的等位基因B/b控制。现有一个随机交配多代的大群体,在某一繁殖季节中孵化了一批子代。其中,芦花公鸡640只,非芦花公鸡360只,芦花母鸡400只,非芦花母鸡600只。不考虑基因突变和致死效应,回答下列问题。
问题:
(1)某同学认为子代中芦花鸡的总数多于非芦花鸡的总数,因此可判断芦花对非芦花为显性。这种判断______(填“正确”或“不正确”)。(3分)
(2)若已知芦花对非芦花为显性,子代中芦花公鸡的基因型为______,其中的纯合子所占比例为______。(6分)
(3)若已知芦花对非芦花为显性,以孵化的这批子代为材料设计实验,验证控制羽色的基因位于Z染色体上。写出杂交方案并预期实验结果。
杂交方案:______________________________;
预期结果:______________________________。(6分)
材料:
【试题】艾滋病是影响人类健康的传染病,科学家和社会对此高度关注,开展了大量的研究,试图在艾滋病的治疗方面有所突破。
(1)下列有关艾滋病的说法正确的是( )。
A.HIV病毒自身无完整酶系
B.HIV病毒具有染色体,遗传物质是RNA
C.HIV病毒只会侵染人体中的辅助性T淋巴细胞
D.父母患艾滋病,其子女也会患病
(2)根据研究的数据(原始数据表格略),画出感染HIV病毒后,人体内HIV病毒的浓度和T细胞数量的变化曲线图。

(3)某研究团队宣布全球首例艾滋病的基因编辑婴儿双胞胎诞生,并称这对双胞胎的一个基因经过修改,他们出生后即可天然抵抗艾滋病。该消息一经报道,立即遭到了社会各界的强烈反对。试分析社会各界强烈反对基因编辑婴儿事件的原因。
问题:
(1)结合材料,分析该试题考查了生物学学科核心素养的哪些方面。(8分)
(2)结合材料,分析编制试题时应遵循的原则。(12分)
材料:
针对“细胞的增殖”一节内容,有两种教学思路。
教学思路一:
环节1:教师为学生培养大蒜根尖,学生根据实验步骤,制作根尖临时装片,观察和描述视野中分裂前后不同阶段的根尖细胞。
环节2:学生以小组为单位进行讨论,对观察到的典型图片进行分裂时期的排序。
环节3:各小组分享排序结果,从如何保证两个子细胞与母细胞遗传物质完全相同的角度进行讨论,并达成共识。
环节4:教师引导学生总结细胞有丝分裂的过程和典型时期的特征。
环节5:教师引导学生总结细胞周期的概况和细胞有丝分裂的意义。
教学思路二:
环节1:教师讲解细胞周期的概况。
环节2:教师为学生展示细胞有丝分裂典型时期的图片,引导学生总结各个时期的特点。
环节3:教师引导学生总结细胞有丝分裂的意义。
环节4:教师组织学生制作和观察大蒜根尖细胞临时装片,观察细胞有丝分裂各个时期的特点。
问题:
(1)分析教学思路一中教师采取了哪些策略帮助学生构建细胞有丝分裂的概念。(10分)
(2)分析教学思路二与课程标准中所倡导的课程理念的一致性。(10分)
缺
